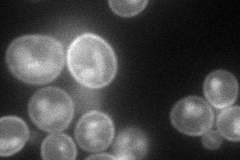
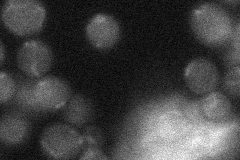
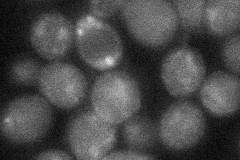

View description
Allantoate permease; ureidosuccinate permease; also transports dipeptides, though with lower affinity than for allantoate and ureidosuccinate; expression is constitutive but sensitive to nitrogen catabolite repression
Localization:
Intensity:
Fold change:
Significance:
-
C’ GFP library in SD

below threshold17.62 -
N' NOP1pr-GFP in SD
cell periphery,vacuole73.6655 -
N' TEF2pr-mCherry in SD

cell periphery,vacuole189.583 -
N' NATIVEpr-GFP in SD
below threshold18.4609 -
N' TEF2pr-VC and Cyto-VN in SD
cell periphery,punctate30.6288 -
C’ GFP library in SD+DTT

cytosol13.080.74No -
C’ GFP library in SD+H2O2

cytosol13.50.76No -
C’ GFP library in Starvation Media

ER54.833.11No -
C’ GFP library on the background of Pup2-DaMP

below threshold -
C’ GFP library on the background of CCT mutant

below threshold15.4050.873712No
